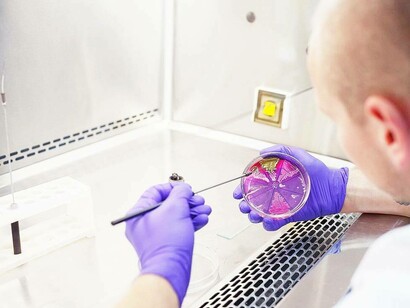
Identificazione di colture pure di microrganismi in laboratorio
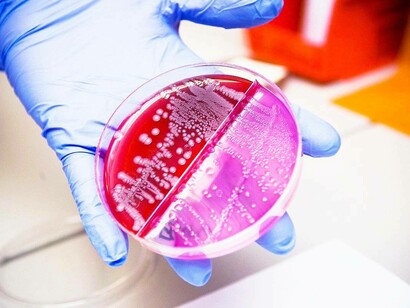
Capsula di Petri contenente il batterio Escherichia coli
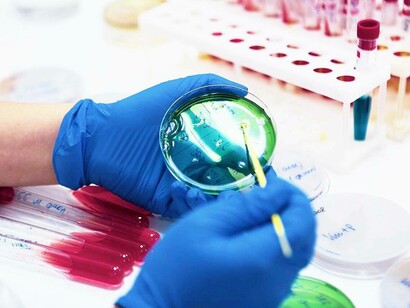
Capsula di Petri in laboratorio, fondamentale strumento di lavoro in molti campi della biologia, per la crescita di colture cellulari e per osservare a occhio nudo colonie batteriche

Un articolo pubblicato sulla rivista Nature riporta la scoperta di una molecola con proprietà antibiotiche diverse da quelle attuali che è stata chiamata lariocidina. Un team di ricercatori guidati dal biochimico Gerry Wright dell'Università McMaster di Hamilton, in Canada, ha identificato questo antibiotico che è da subito stato considerato una nuova classe. Si tratta di un risultato che è stato raggiunto analizzando campioni di suolo di un giardino di un tecnico di laboratorio dell'università i quali sono stati successivamente coltivati in laboratorio.
La lariocidina è prodotta anch'essa da un batterio appartenente al genere Paenibacillus e i test hanno mostrato che è efficace contro altri batteri, anche di specie che hanno sviluppato una resistenza agli antibiotici attuali. Rimane il problema, non da poco, della sua produzione a livello industriale.
Il crescente problema della resistenza agli antibiotici è ormai un'emergenza medica. Un'analisi pubblicata l'anno scorso sulla rivista Lancet indica che già negli anni '90 il numero di morti causate da infezioni dai cosiddetti superbatteri aveva superato il milione l'anno. Ci sono rischi serissimi che la situazione peggiori nei prossimi anni con la crescita dei ceppi batterici resistenti. Servono nuovi tipi di antibiotici che utilizzino meccanismi d'attacco diversi da quelli attuali e il team di Gerry Wright è convinto di averne trovato uno molto promettente.
Uno dei metodi di ricerca di nuove molecole consiste nel cercarle in natura, ad esempio tra quelle utilizzate da microrganismi che le impiegano normalmente, in questo caso per eliminare specie con cui competono. Nel suolo noi vediamo normalmente solo piante e piccoli animali ma in realtà anche vicino alla superficie gli ecosistemi includono anche grandi quantità di microrganismi che possono richiedere studi complessi per studiarli.
Ricerche condotte negli ultimi anni hanno dimostrato che il suolo potrebbe contenere le comunità microbiche più diversificate del mondo. Esse costituiscono la spina dorsale degli ecosistemi, al punto che sono cominciate ricerche mirate per capire se il suolo di un certo territorio contenga un sano microbioma perché tra le altre cose è la chiave per un'agricoltura sostenibile. La ricchezza del microbioma del suolo può costituire un tesoro anche per la ricerca medica.
La ricerca condotta all'Università McMaster è partita dalla raccolta di campioni di suolo dal giardino di un tecnico di laboratorio. Successivamente, i microrganismi al loro interno sono stati coltivati in capsule di Petri, recipienti standard in questo tipo di lavoro biologico, per un anno.
Alla fine di questo processo lungo ma necessario per ottenere grandi quantità di microrganismi per gli esperimenti, i ricercatori li hanno esposti a campioni di Escherichia coli, batteri molto comuni e molto usati in studi biologici. Il risultato è stato che batteri appartenenti al ceppo catalogato come Paenibacillus sp. M2 hanno ucciso gli Escherichia coli. Ciò è avvenuto grazie a un peptide, cioè una molecola composta da una catena di amminoacidi, paragonata a un lazo da cowboy per la sua forma con un anello che ha una sorta di coda. Si tratta proprio della molecola che è stata chiamata lariocidina.
Non è la prima molecola conosciuta che ha quel tipo di forma dato che ne sono conosciute altre da diversi decenni. Tuttavia, la lariocidina ha mostrato questi effetti antibatterici davvero interessanti che hanno ripagato l'anno di sforzi impiegato per coltivare i Paenibacillus da parte del team di Gerry Wright.
Il meccanismo antibiotico della lariocidina è basato sul fatto che essa si lega al ribosoma e all'RNA dei batteri che vengono colpiti. Ciò impedisce che l'RNA formi correttamente le proteine che servono al batterio per vivere e anzi il ribosoma finisce per produrre peptidi che sono tossici per il batterio. Si tratta di un meccanismo diverso da quello degli antibiotici usati finora e per questo motivo Gerry Wright e i suoi colleghi ritengono che la lariocidina costituisca una nuova classe di questi medicinali.
I meccanismi della lariocidina non dovrebbero causare danni alle cellule umane e ciò costituirebbe un'altra ottima notizia. Ciò andrà comunque certificato tramite i test clinici necessari all'approvazione di qualsiasi farmaco. Si tratta di test che vengono condotti in varie fasi per ottenere la ragionevole certezza dell'efficacia del nuovo farmaco e per scoprire i possibili effetti collaterali. Inevitabilmente, ciò richiede tempo.
Un problema a livello pratico è dato dalla necessità di produrre lariocidina a livello industriale, cosa che sembra impossibile solo dalla coltivazione dei batteri Paenibacillus. Si tratta di una molecola complessa e quindi di dimensioni notevoli in rapporto a quella scala microscopica. Per questo motivo, il team di Gerry Wright sta esaminando la possibilità di ridurre la lariocidina eliminando amminoacidi inutili nell'azione antibatterica. Ciò potrebbe aprire le porte a possibilità di sintesi chimica della molecola ma anche questo potrebbe essere un lavoro davvero lungo.
Poter produrre un nuovo antibiotico per il quale non risulta esistere alcuna forma di resistenza da parte dei superbatteri aiuterebbe a salvare moltissime vite. Ciò però era vero anche per i vecchi antibiotici che sono stati introdotti nel corso dei decenni passati e hanno progressivamente perso efficacia. L'eccessivo utilizzo di antibiotici ha forzato l'evoluzione dei batteri facendo emergere i mutanti dotati di forme di resistenza.
Un articolo pubblicato sulla rivista Proceedings of the National Academy of Sciences (PNAS) Nexus ha stimato i residui di antibiotici che non vengono metabolizzati ma vengono espulsi e finiscono nei fiumi di tutto il mondo, generando ormai una forma di inquinamento che può alterare i loro ecosistemi. In sostanza, il problema del cattivo uso di antibiotici ha varie ramificazioni.
La lezione che dovremmo deciderci a imparare è che una nuova classe di questi medicinali come potrebbe essere la lariocidina potrebbe essere preziosa per salvare moltissime vite ma il loro corretto utilizzo, solo quando servono davvero per combattere un'infezione batterica, è fondamentale per evitare di ritrovarsi con gli stessi problemi nel giro di qualche anno.